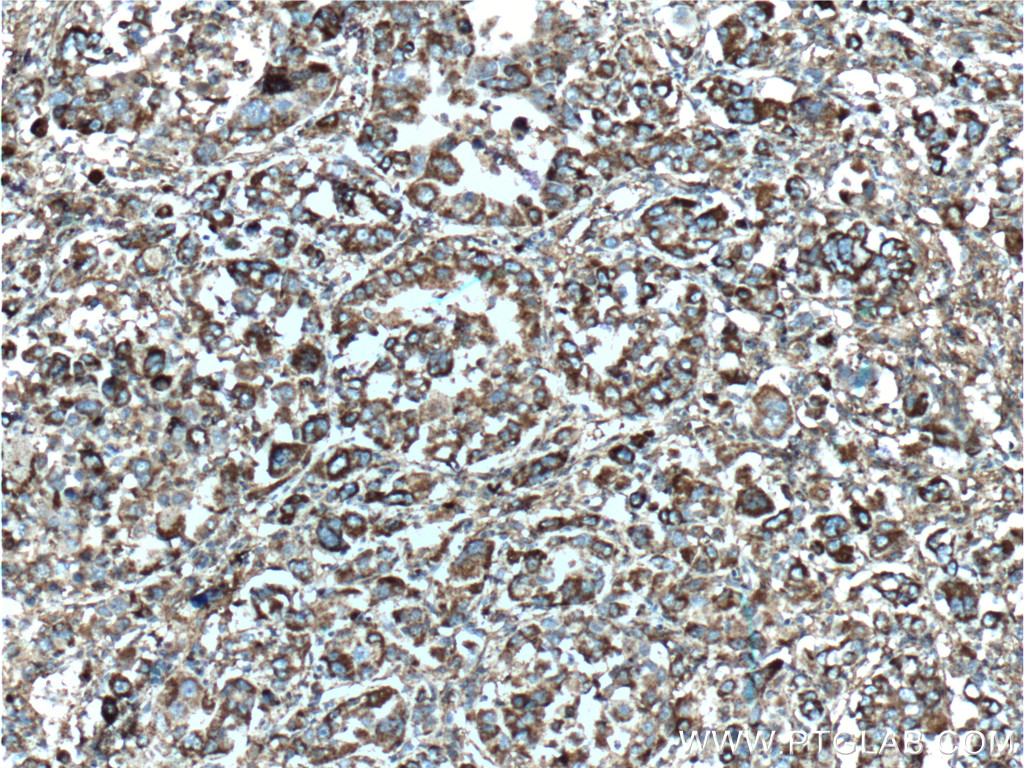

验证数据展示
经过测试的应用
| Positive WB detected in | IFN gamma, LPS and Brefeldin A treated THP-1 cells |
| Positive IHC detected in | human hepatocirrhosis tissue, human liver cancer tissue, human nasopharyngeal carcinoma tissue, human ovary tumor tissue Note: suggested antigen retrieval with TE buffer pH 9.0; (*) Alternatively, antigen retrieval may be performed with citrate buffer pH 6.0 |
推荐稀释比
| 应用 | 推荐稀释比 |
|---|---|
| Western Blot (WB) | WB : 1:500-1:2000 |
| Immunohistochemistry (IHC) | IHC : 1:200-1:800 |
| It is recommended that this reagent should be titrated in each testing system to obtain optimal results. | |
| Sample-dependent, Check data in validation data gallery. | |
产品信息
10937-1-AP targets CXCL10/IP-10 in WB, IHC, IF, ELISA applications and shows reactivity with human samples.
| 经测试应用 | WB, IHC, ELISA Application Description |
| 文献引用应用 | WB, IHC, IF |
| 经测试反应性 | human |
| 文献引用反应性 | human, mouse, rat |
| 免疫原 |
CatNo: Ag1369 Product name: Recombinant human CXCL10 protein Source: e coli.-derived, PGEX-4T Tag: GST Domain: 1-98 aa of BC010954 Sequence: MNQTAILICCLIFLTLSGIQGVPLSRTVRCTCISISNQPVNPRSLEKLEIIPASQFCPRVEIIATMKKKGEKRCLNPESKAIKNLLKAVSKERSKRSP 种属同源性预测 |
| 宿主/亚型 | Rabbit / IgG |
| 抗体类别 | Polyclonal |
| 产品类型 | Antibody |
| 全称 | chemokine (C-X-C motif) ligand 10 |
| 别名 | CXCL10, CXCL10/IP10, IP10, 10 kDa interferon gamma-induced protein, C X C motif chemokine 10 |
| 计算分子量 | 11 kDa |
| 观测分子量 | 11 kDa |
| GenBank蛋白编号 | BC010954 |
| 基因名称 | CXCL10 |
| Gene ID (NCBI) | 3627 |
| RRID | AB_2088002 |
| 偶联类型 | Unconjugated |
| 形式 | Liquid |
| 纯化方式 | Antigen affinity purification |
| UNIPROT ID | P02778 |
| 储存缓冲液 | PBS with 0.02% sodium azide and 50% glycerol, pH 7.3. |
| 储存条件 | Store at -20°C. Stable for one year after shipment. Aliquoting is unnecessary for -20oC storage. |
背景介绍
CXCL10 (also known as IP-10) is a member of the CXC chemokine family which binds to the CXCR3 receptor to exert its biological effects. CXCL10 is a 12-kDa protein and constitutes two internal disulfide cross bridges. The predicted signal peptidase cleavage generates a 10-kDa secreted polypeptide with four conserved cysteine residues in the N-terminal. The CXCL10 gene localizes on chromosome 4 at band q21, a locus associated with an acute monocytic/B-lymphocyte lineage leukemia exhibiting translocation of t (4; 11) (q21; q23). CXCL10 mediates leukocyte trafficking, adaptive immunity, inflammation, haematopoiesis and angiogenesis. Under proinflammatory conditions CXCL10 is secreted from a variety of cells, such as leukocytes, activated neutrophils, eosinophils, monocytes, epithelial cells, endothelial cells, stromal cells (fibroblasts) and keratinocytes in response to IFN-γ.
实验方案
| Product Specific Protocols | |
|---|---|
| IHC protocol for CXCL10/IP-10 antibody 10937-1-AP | Download protocol |
| WB protocol for CXCL10/IP-10 antibody 10937-1-AP | Download protocol |
| Standard Protocols | |
|---|---|
| Click here to view our Standard Protocols |
发表文章
| Species | Application | Title |
|---|---|---|
Cancer Lett PARP inhibitor plus radiotherapy reshape the immune suppressive microenvironment and potentiate the efficacy of immune checkpoint inhibitors in tumors with IDH1 mutation | ||
J Mater Chem B Magnetic hyperthermia induces effective and genuine immunogenic tumor cell death with respect to exogenous heating | ||
Front Immunol LRPPRC facilitates tumor progression and immune evasion through upregulation of m6A modification of PD-L1 mRNA in hepatocellular carcinoma | ||
Cancer Commun (Lond) KRAS-G12D mutation drives immune suppression and the primary resistance of anti-PD-1/PD-L1 immunotherapy in non-small cell lung cancer. | ||
CNS Neurosci Ther Melatonin Alleviates Behavioral and Neurodevelopmental Abnormalities in Offspring Caused by Prenatal Stress | ||
Am J Cancer Res Identification of potential immune-related circRNA-miRNA-mRNA regulatory network in cutaneous squamous cell carcinoma |